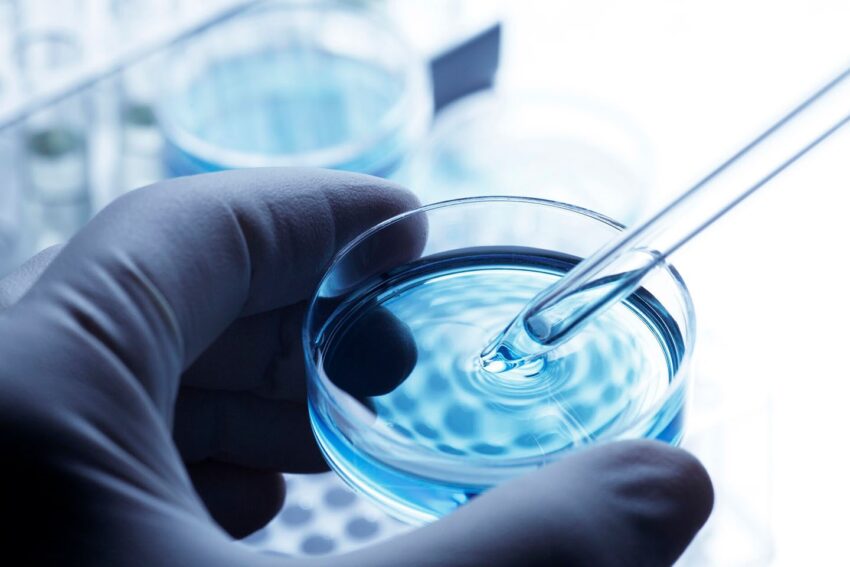

The pharmaceutical water market consists of water purification systems used across various applications in the pharmaceutical industry. Pharmaceutical-grade water purification ensures sterile and high-purity water for injection, cleaning of equipment and facilities, and other critical applications where microbial and particulate contamination can compromise product quality and safety. With stringent regulations governing water quality standards in pharmaceutical manufacturing, there is growing investment in sophisticated water treatment technologies such as ultrafiltration, reverse osmosis, ion exchange, and UV oxidation systems that remove particulate matter, purify water, and deliver sterile water on-demand.
The global Pharmaceutical Water Market is estimated to be valued at US$ 6.26 Bn in 2023 and is expected to exhibit a CAGR of 7.9% over the forecast period 2023 to 2030, as highlighted in a new report published by Coherent Market Insights.
Market key trends:
One of the key drivers of the pharmaceutical water market is the growing investment by pharmaceutical companies in advanced water purification solutions. Stringent regulations mandating high-purity water standards for critical manufacturing applications is driving the demand for technologies such as ultrafiltration and reverse osmosis that deliver sterile, high-purity water with low levels of microorganisms and contaminants. Leading pharmaceutical players are increasingly undergoing capacity expansion and upgrading water treatment infrastructure to meet evolving quality norms and handle higher production volumes, which is propelling the pharmaceutical water treatment market.
SWOT Analysis
Strength: Pharmaceutical water has high growth rate owing to increase in healthcare spending along with increasing number of manufacturing facilities. Additionally, stringent regulations regarding pharmaceutical water purity further drive the market growth.
Weakness: Complex water treatment processes required for pharmaceutical applications increase the operational cost of production. Manual operations involved also increase chance of human errors.
Opportunity: Emerging nations in Asia and Latin America exhibit high potential for market growth due to increasing economic conditions. Collaborations between market players and end users can further explore new opportunities.
Threats: Threat from substitute products like pharmaceutical grade hydrogen peroxide and ozone exist. Growing trade protectionism also poses threat to global market.
Key Takeaways
The Global Pharmaceutical Water Market Size is expected to witness high growth during the forecast period due to increasing demand for purified water across production, research and other activities. Regionally, North America dominates currently owing to presence of majority of key players and stringent regulations regarding water usage in pharmaceutical industry. Asia Pacific is estimated to witness fastest growth in pharmaceutical water market due to rapidly expanding pharmaceutical industry in countries like India and China.
Key players operating in the pharmaceutical water market include Sartorius, Merck KGaA, Thermo Fisher Scientific Inc., GENERAL ELECTRIC, Danaher Corporation, SUEZ Water Technologies & Solutions, Veolia Water Solutions and Technologies, Evoqua Water Technologies LLC, Aqua Solutions, Inc., Baxter International Inc.
*Note:
1. Source: Coherent Market Insights, Public sources, Desk research
2. We have leveraged AI tools to mine information and compile it